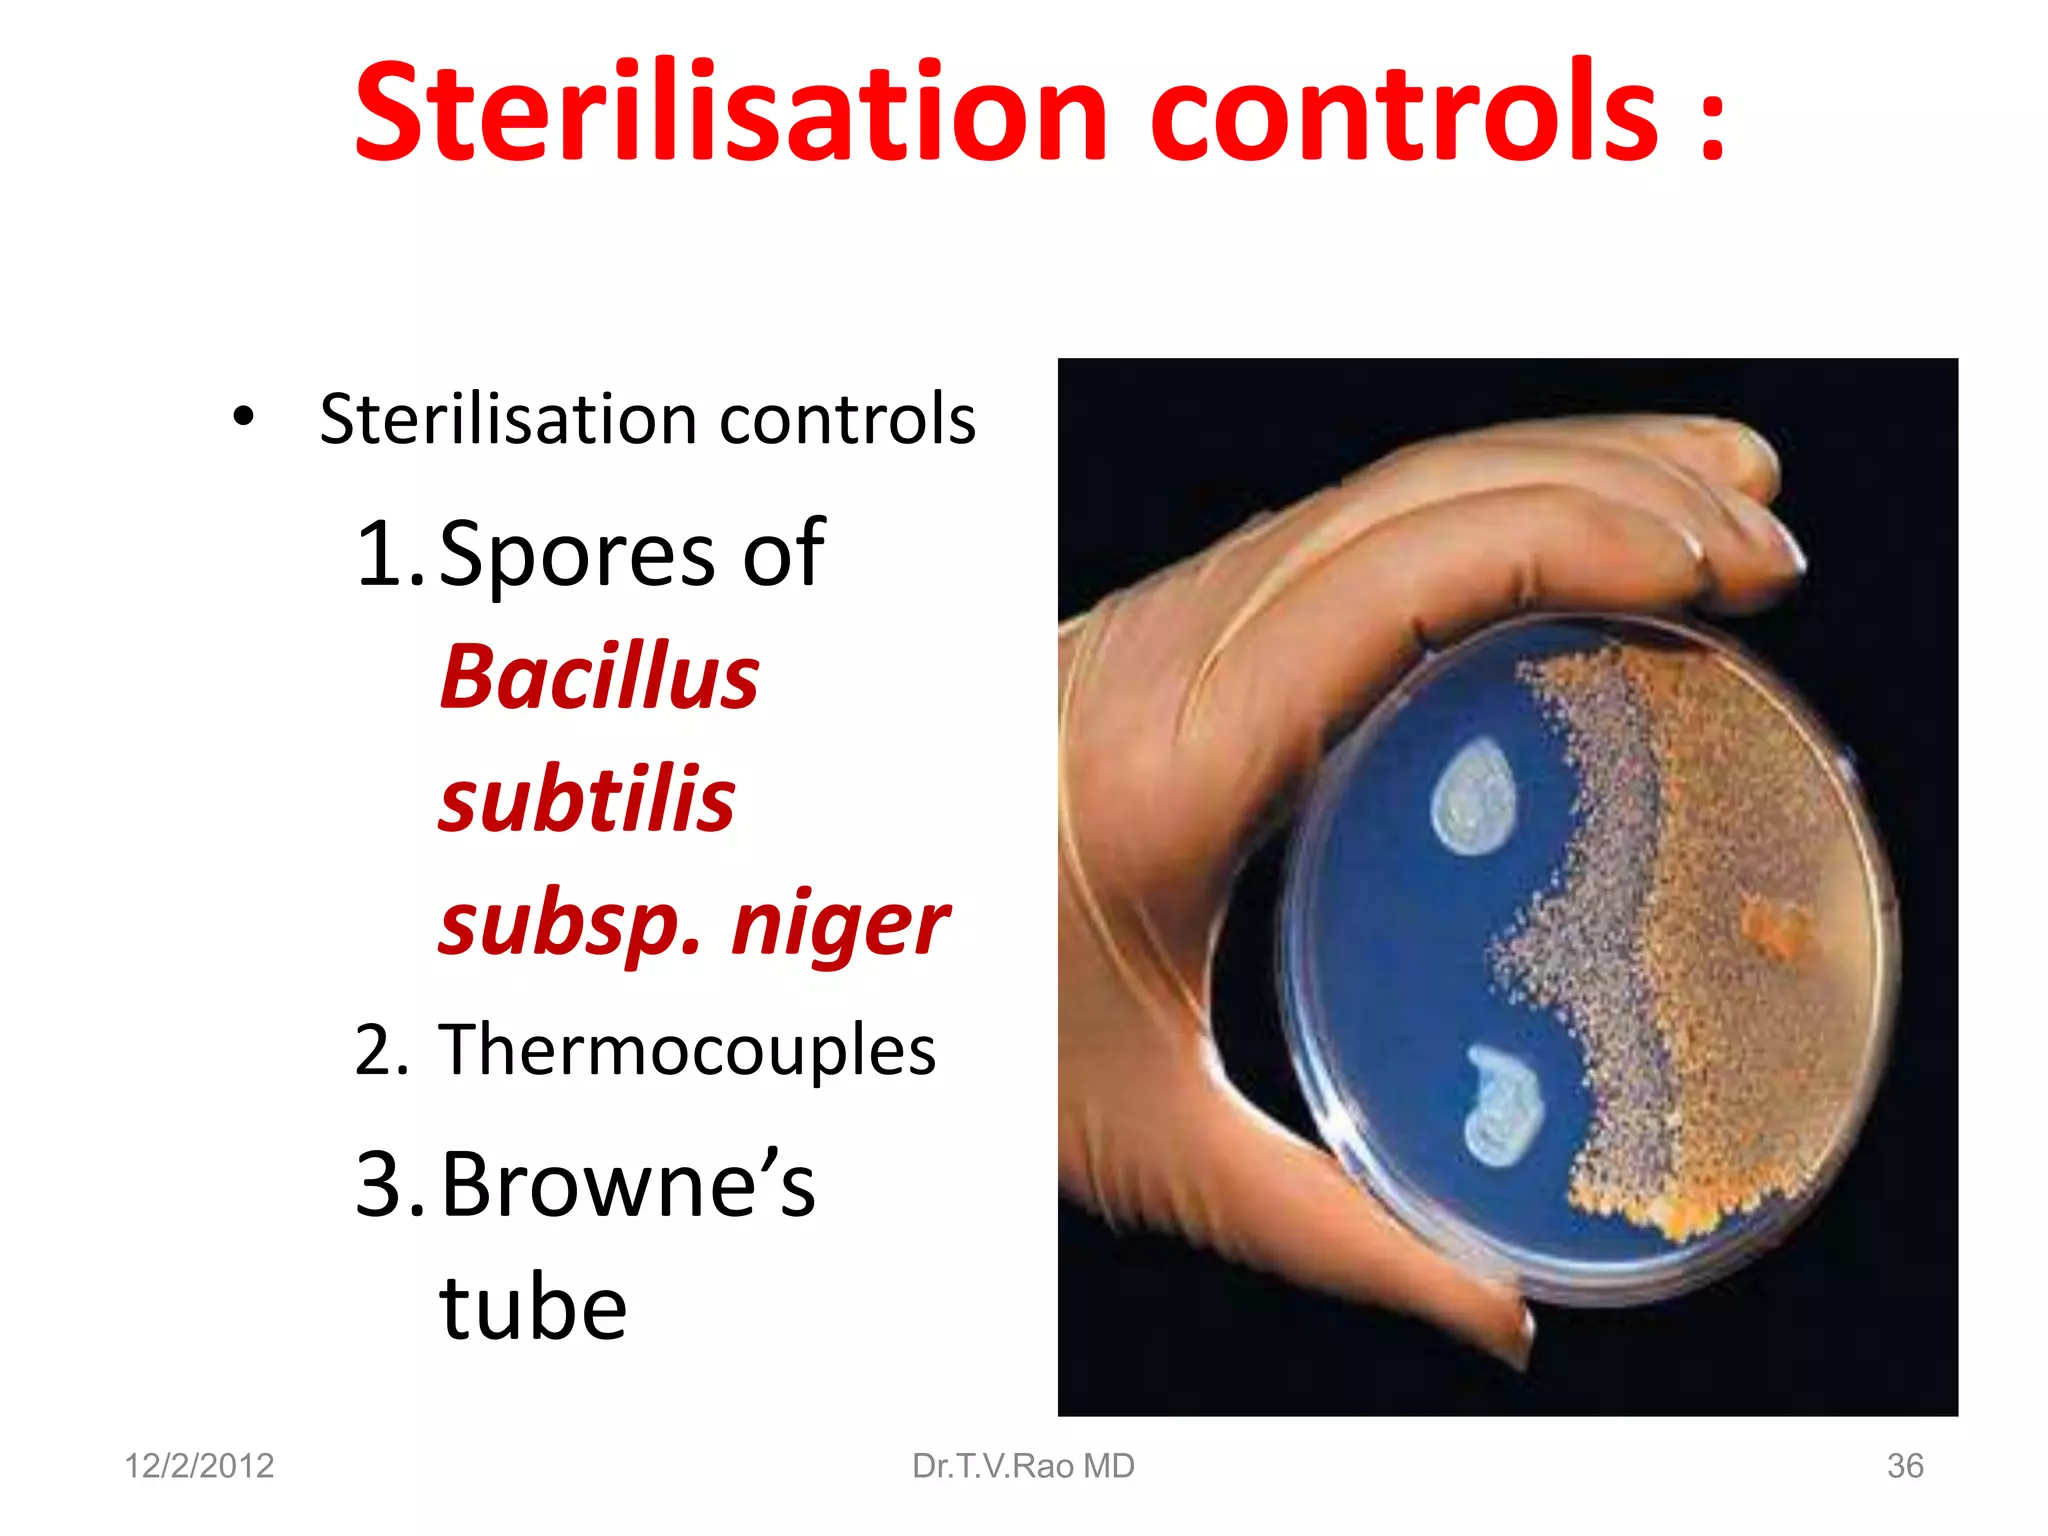
Sterilisation controls :
      • Sterilisation controls
            1.Spores of
              Bacillus
              subtilis
              subsp. niger
            2. Thermocouples
            3.Browne’s
              tube
12/2/2012                  Dr.T.V.Rao MD   36

This document discusses various physical sterilization methods. It begins by explaining why sterilization is needed to remove or destroy microorganisms that can cause infection. It then describes different physical sterilization techniques like heat, radiation, and filtration. It provides details on specific heat-based methods for sterilizing different materials and lists the most common physical sterilization methods.